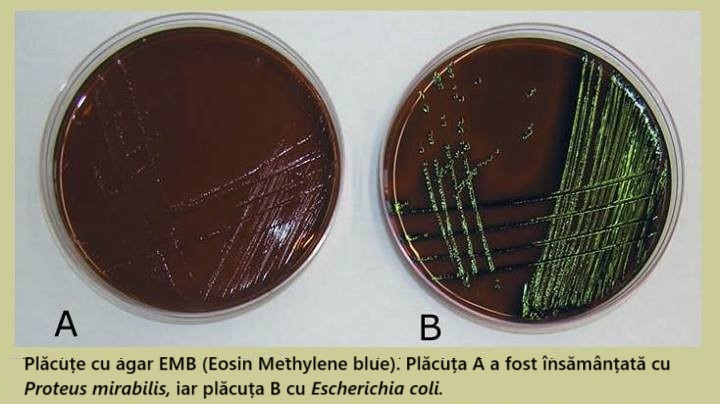

EMBDr. Stănescu: Haideți să discutăm mai mult despre asta. De ce credeți că EMB este o opțiune bună pentru acest mediu? Sorin: M-am gândit să folosesc EMB deoarece ajută la diferențierea fermenților de lactoză, ceea ce ar fi util dacă suspectăm agenți patogeni specifici, cum ar fi E. coli . Credeam că E. coli este o cauză frecventă a intoxicațiilor alimentare. Tu: E un punct de vedere bun, Sorin. EMB facilitează diferențierea pentru fermenții de lactoză Gram-negativi, deoarece produc acel luciu verde metalic distinct. Dar crezi că este potrivit pentru detectarea tuturor bacteriilor? Nu putem face nicio presupunere în acest moment și trebuie să folosim o gamă mai largă de indicatori.
Creștere bacteriană pe mediu EMB: Plăcile A și B prezintă rezultate negative, respectiv pozitive ale testelor. Website: https://www.medical-labs.net/eosin-methylene-blue-agar-emb-833/#google_vignette
Dr. Stănescu: Exact, asta e ceva de luat în considerare, dacă contaminarea include bacterii Gram-pozitive sau non-fermentatori de lactoză, este posibil ca acestea să nu crească deloc pe EMB. Sorin: Deci, dacă am folosi EMB, am putea rata alte tipuri de bacterii prezente în probă și am limita evaluarea contaminării bacteriene totale. Tu: Corect. Pentru o verificare generală a contaminării, un mediu neselectiv ar fi o alegere mai potrivită, deoarece poate identifica o gamă mai largă de bacterii. Dr. Stănescu: Corect. Hai să mai încercăm! |
Map: CS11 - CULTURA ȘI CREȘTEREA MICROBIANĂ - ROMANIAN (1053)
|
||
|
Review your pathway |